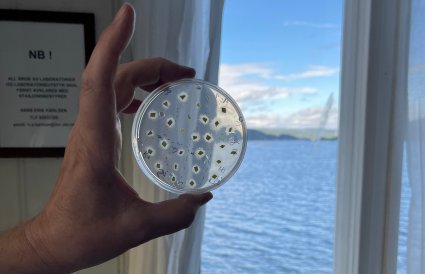

Hittil ukjente parasitter har fått fotfeste i Oslofjorden
Mens alles øyne har vært rettet mot næringssalter, lurv og fiskeri, har en hittil ukjent trussel vokst seg stor i Oslofjorden. Dette kan føre til sykdom og store problemer for allerede hardt pressede tangsamfunn og ålegrasenger.
– Se her, da. Nekrose på tangen. Vi kan se at bladene er misfarget med røde, gulaktige og svarte flekker, et tydelig tegn på syk tang.
På Nesset på Hurumlandet i Oslofjorden står NIVA-forsker Marit F. Markussen Bjorbækmo og leter i fjæra. Hun peker på den brune blæretangen og forklarer.
– Først var det en viss entusiasme over å finne noe nytt og ukjent. Samtidig var overraskelsen stor over å finne så mange forskjellige arter av disse mikroskopiske parasittene. Dette er en type parasitter som kan forårsake svært alvorlige sykdomsutbrudd, sier hun.
Marit forteller om lignende sykdomstegn også i ålegraset i Sandspollen i Asker like i nærheten. Typisk ser det normalt ut ved første øyekast, med friske, grønne blader. Men rotsystemet har mange synlige tegn på sykdom. Dette svekker plantenes evne til å forankre seg i sedimentene og øker risikoen for at de dør.
Også i andre ålegrasenger lenger inn i Oslofjorden, er det funnet det samme: ålegras med mørke, døde flekker på bladene, og i rotsystemet. Nekrose kalles det på fagspråket, og innebærer lokal celle- og vevsdød.
Det mest overraskende var imidlertid at undersøkelser av tilsynelatende friske planter også avdekket de ukjente parasittene. I de aller fleste prøvene.
«Parasitus incognitus»
Denne sommeren har NIVA stått i spissen for arbeidet med å avdekke en helt ny type parasitter i Oslofjorden, som lyder navnet oomyceter.
Funnene er gjort i to prosjekter. Det ene har fokus på tang og tare, og er finansiert av Artsdatabanken. Det andre prosjektet dreier seg om ålegras, og er finansiert av Bymiljøetaten i Oslo kommune. I sistnevnte er det Norsk institutt for bioøkonomi (NIBIO) som har stått for undersøkelsene i laboratorium.
Resultatene tyder på at oomycet-parasitter kan være et betydelig og fullstendig oversett problem i den allerede hardt pressede fjorden vår.
– Det er klart at dette ikke er en nyhet den allerede syke Oslofjorden trenger nå, sier Marit.
– Når vi får treff alle stedene vi analyserer på, er det liten tvil om at dette er utbredt.
Den erfarne forskeren mener det er svært viktig å kartlegge dette videre. Enn så lenge finnes det ingen overvåkningsprogrammer som inkluderer mikroorganismer, men etter Marits mening er dette noe forvaltningen burde vurdere å ta med.
− Vi vet ikke hvor de finnes, fordi vi ikke har lett. I hvert fall ikke i marine miljøer. Men nå vet vi at de er i Oslofjorden.
Marit tror også at disse parasittene, i beste fall, er medskyldige i mye elendighet.
I verste fall er det rød alarm fra Vippetangen til Færder.
Fakta om mikroorganismer
Enhver organisme (fra mennesker til tang og børstemark) har mikroorganismer som lever sammen med dem, både på overflaten og innvendig. Dette samspillet mellom en vert og alle dens mikroorganismer (holobiont-konseptet, som det kalles) er helt avgjørende for vertens helse. Eksempelvis er en god tarmflora svært viktig hos oss mennesker.
En ubalanse i samfunnet av mikroorganismer kalles på fagspråket for «dysbiose». Dette kan være forårsaket av både endringer i miljøet eller hvis verten er svekket på annet vis.
Ifølge NIVA-forsker Marit F. Markussen Bjorbækmo vil det dårlige miljøet i den allerede syke Oslofjorden også gi endringer i samfunnene av mikroorganismer. Og når dette skjer, er arter som tang og ålegras trolig enda mer mottakelige for angrep av parasitter som oomyceter.

Spennende – og skummelt
Så langt har vi altså svært begrenset kunnskap om marine oomyceter i Norge. Vi vet at de enten fungerer som nedbrytere, som bryter ned og spiser dødt materiale, eller som parasitter på planter, dyr og alger.
– Noen av dem kan føre til alvorlige konsekvenser for både miljø og økonomi, for eksempel ved å forårsake sykdommer hos laks eller ved at de på landjorda ødelegger avlinger. Imidlertid har vi hittil nesten ingen informasjon om oomyceter i marine miljøer. Vi vet lite om mangfold, hva de gjør, eller hvor de kommer fra, sier Marit.
I Artsdatabanken er det ikke registrert noen marine kystnære arter. Grunnleggende informasjon om taksonomi og epidemiologi er en «black box».
I skrivende stund er Marit i gang med et prosjekt som står for det som er den aller første systematiske kartleggingen av utbredelse av oomyceter i tang. I OOMYCOAST-prosjektet, som er finansiert av Artsdatabanken, ser Marit og hennes team på brunalger, som blæretang, grisetang og sagtang. Stasjonen på Nesset i Oslofjorden (se kart over) er ett av stedene som inngår i feltarbeidet.
Forskerne har allerede funnet et stort antall ulike oomyceter.
– Det er tydelig at her er det en stor diversitet av oomyceter som vi ikke kjenner til. Vi vet ikke hvordan de påvirker algene, forklarer Marit.
Om oomyceter også kan være en medvirkende faktor til at tang, tare og ålegras sliter andre steder langs kysten vår, er helt ukjent.
– Dette er nybrottsarbeid. Det er derfor det er så spennende, men også litt skummelt. Vi aner ikke hva som venter oss.

Skyhøy smittefare
En ting NIVA-forskeren imidlertid er sikker på, er at det er vanskelig å stanse parasittene i frie vannmasser. Tenk deg covid, men med null smittevernstiltak. Énmetersregelen kan ingen overholde i tette ålegrasenger og tangsamfunn. Når en ålegrasplante infiseres med en oomycet-parasitt, tror derfor Marit det er umulig for resten av enga å slippe unna.
– Spredningsenheten til oomyceter, som kalles zoosporer, er avhengig av vann for å kunne svømme til en ny vert de kan infisere. På landjorda er spredningsfaren stor via regnvann, bekker og elver, så det er sannsynlig at den er det mangedoblete i marine miljøer.
At smittefaren er stor i ålegrasengene, underbygges i en rykende fersk rapport fra NIBIO. Den viser at samtlige av de seks ålegrasengene som ble undersøkt i Oslofjorden i mai og juni, bærer oomycet-smitte.
Undersøkelsene ble utført som en del av et naturrestaureringsprosjekt finansiert av Bymiljøetaten i Oslo kommune og ledet av NIVA, med Kristina Øie Kvile som prosjektleder.
Det var NIBIO-forsker Martin Pettersson som stod for undersøkelsene i laboratorium.
– Totalt var det vekst av oomyceter fra et stort antall prøver. Utveksten var størst fra rotstengler og finrøtter, men mange hadde vekst også fra bladene, sier Martin.
Forskeren fra NIBIO, som har jobbet mye med oomyceter og mikroorganismer på landjorda, er også tydelig på at vi trenger mer kunnskap om oomycetene i Oslofjorden.
– På land kjenner vi til at flere arter innen artsgruppen oomyceter er alvorlige plantepatogener, men vi vet lite om de marine artene. Det er derfor stort behov for mer forskning for å avklare deres skadepotensiale, sier han.
Mer informasjon med DNA-metoder
For å gjøre saken enda litt mer komplisert, er det slett ikke sikkert at de ferske laboratorieundersøkelsene avdekker alle omycetene som finnes på den undersøkte tangen og ålegraset.
Marit forklarer at det finnes en hel masse forskjellige arter av oomycet-parasitter – og at metodene som hittil er brukt i Oslofjorden «kun» viser diversiteten av oomyceter som lar seg dyrke. Siden mange mikroorganismer, inkludert flere oomyceter, ikke kan dyrkes, kan det bety at diversiteten av oomyceter i ålegras og tang er enda større enn det som avdekkes ved dyrking.
Ifølge Marit ligger løsningen i å bruke molekylære metoder, som DNA-analyser, i kombinasjon med dyrking. Først da kan man avdekke «alle» oomycetene som skjuler seg i ålegraset og tangen.
Beryktet gruppe
Marit forteller videre om krepsepest, en slags fjern og ganske så fryktet fetter i oomycet-gruppa. Den er harmløs i amerikanske farvann, men dødelig på denne siden av Atlanteren.
Aphanomyces astaci, som den heter på latin, lever naturlig i skallet til nordamerikanske ferskvannskreps. I sitt hjemlige miljø har krepsdyras immunforsvar tilpasset seg parasitten over tid, slik at de ikke blir syke av den. For europeiske ferskvannskreps er situasjonen derimot en helt annen.
Disse europeiske krepsene har aldri tidligere vært i kontakt med A. astaci og har derfor ikke utviklet noe forsvar mot parasitten. Så når folk, ulovlig, setter ut nordamerikanske kreps, som den beryktede signalkrepsen, i våre vann – senest nå i august i Øyeren – har disse krepsene hatt med seg den dødelige parasitten på skallet sitt.
– Resultatet er at våre ferskvannskreps blir smittet, og for dem er sykdommen en dødsdom. Krepsepesten sprer seg raskt og er hundre prosent dødelig, forklarer Marit.

Oomycetene i Oslofjorden slår nok forskjellig ut på ulike arter. Hvordan, det vet vi ikke ennå.
Hungersnød og flukt
Oomycetenes kanskje største kjendis finner vi imidlertid på landjorda, nærmere bestemt i potetåkeren. Potettørråten, Phytophthora infestans, er en annen av oomycetenes verstinger. Du vet, den som i 1840-årene førte til at potetavlingene i Irland ble totalt ødelagt, med enorme konsekvenser. Det regnes med at minst en million mennesker sultet i hjel i den påfølgende hungerkatastrofen, og at to millioner emigrerte til USA.
Får potettørråten først feste i åkeren kan hvilesporene overleve i jorda i minst fem vintre før de dør. Det er imidlertid trolig lite sammenlignet med i marine miljøer, der spredningspotensialet er enormt mye større.
I Oslofjorden tror Marit derfor at oomycetene er kommet for å bli.
Så hva gjør vi da? Hvor lang tid tar det å bli kvitt dem? Eller må vi lære oss å leve med dem? Vil «våre» arter bli immune?
– Det vet vi ikke. Vi har mange spørsmål, men ikke like mange svar. Oomycetene i Oslofjorden slår nok også forskjellig ut på ulike arter. Hvordan, det vet vi ikke ennå.
Mitt skip er lastet med …
Det er ingen lett oppgave å finne ut om disse oomycetene allerede har vært her i lang tid, eller om de er nyankomne i Oslofjorden. Men fra tidligere er det mange eksempler på nye arter og organismer som kommer sjøveien som blindpassasjerer i ballasttanken på skip. Derfor er det så viktig å rense ballastvann.
Japansk drivtang og nordamerikansk ribbemanet er eksempler på invaderende arter vi har i norske farvann, som kom hit nettopp med ballastvann.
– Ettersom vi vet at mange andre organismer har kommet hit med ballastvann, er det høyst sannsynlig at det har blitt sluppet ut massevis av oomyceter og andre mikroorganismer som kan forårsake sykdommer hos våre hjemlige arter, sier Marit.
Kunsten å fange en oomycet
Marits bakgrunn gjør henne godt egnet til å finne løsninger for å forstå mer om disse nyoppdagete marine oomycetene. Men før man kan studere dem, må man først fange dem.
I «verktøykassa» si har NIVA-forskeren og hennes team en rekke muligheter.
– Vi kan benytte både molekylære/DNA-metoder, og direkte dyrking av oomyceter ut fra vevet til ålegras og tang. En annen, mer kreativ, metode er å lage feller for å fange oomycetene. Deretter dyrkes de i kultur. Slik kan vi ved hjelp av mikroskop og molekylære metoder undersøke hvilke arter av oomyceter vi har fanget, forklarer hun.
I sommer holdt hun en oomycet-workshop i Drøbak, med deltagere fra både nasjonale og internasjonale forskningsinstitusjoner. Samarbeidspartnere Thomas Jung og Marília H. Jung, begge verdensledende oomycet-eksperter fra Mendel University i Brno, Tsjekkia, kom for å gi opplæring i hvordan fange og dyrke oomyceter.
I løpet av seks dager samlet deltagerne inn prøver fra både ålegras og tang, utplasserte feller og isolerte oomyceter fra disse. «Fangsten» var på over 300 kulturer av oomyceter.
– Disse studeres i skrivende stund nøye i laboratoriet og vil danne et viktig kunnskapsgrunnlag i å lære mer om Oslofjordens oomyceter, sier Marit.
Døden for Oslo f?
Så, er løpet nå kjørt for Oslofjorden? Er oomycet-parasittene den endelige spikeren i kista? Nei da, Marit ser ikke så svart på det. For henne er det viktig å få frem at alle de godt kjente tiltakene som er lansert for å friskmelde fjorden, fremdeles er viktige.
Marit ser oomycet-invasjonen som en del av det store bildet, én trussel i en rekke av andre trusler. Hun understreker at fjorden vil håndtere parasittene bedre dersom tilstanden bedres. Akkurat som pasienten med sterk allmenntilstand takler sykdom bedre, vil en fjord med godt «immunforsvar» stå sterkere imot angrep fra parasitter og patogener.
– Akkurat nå fremstår fjorden som svekket, og dermed som et lettere offer for parasitter. Den beste måten å hindre disse opportunistiske mikroorganismene fra et kraftfullt angrep, er å gjøre det vi kan for at artene som lever i fjorden får økt motstandskraft. Tiltakene for å redde fjorden er derfor viktigere enn noen gang å prioritere, sier NIVA-forskeren.
 Marit Frederikke Markussen Bjorbækmo
Marit Frederikke Markussen Bjorbækmo